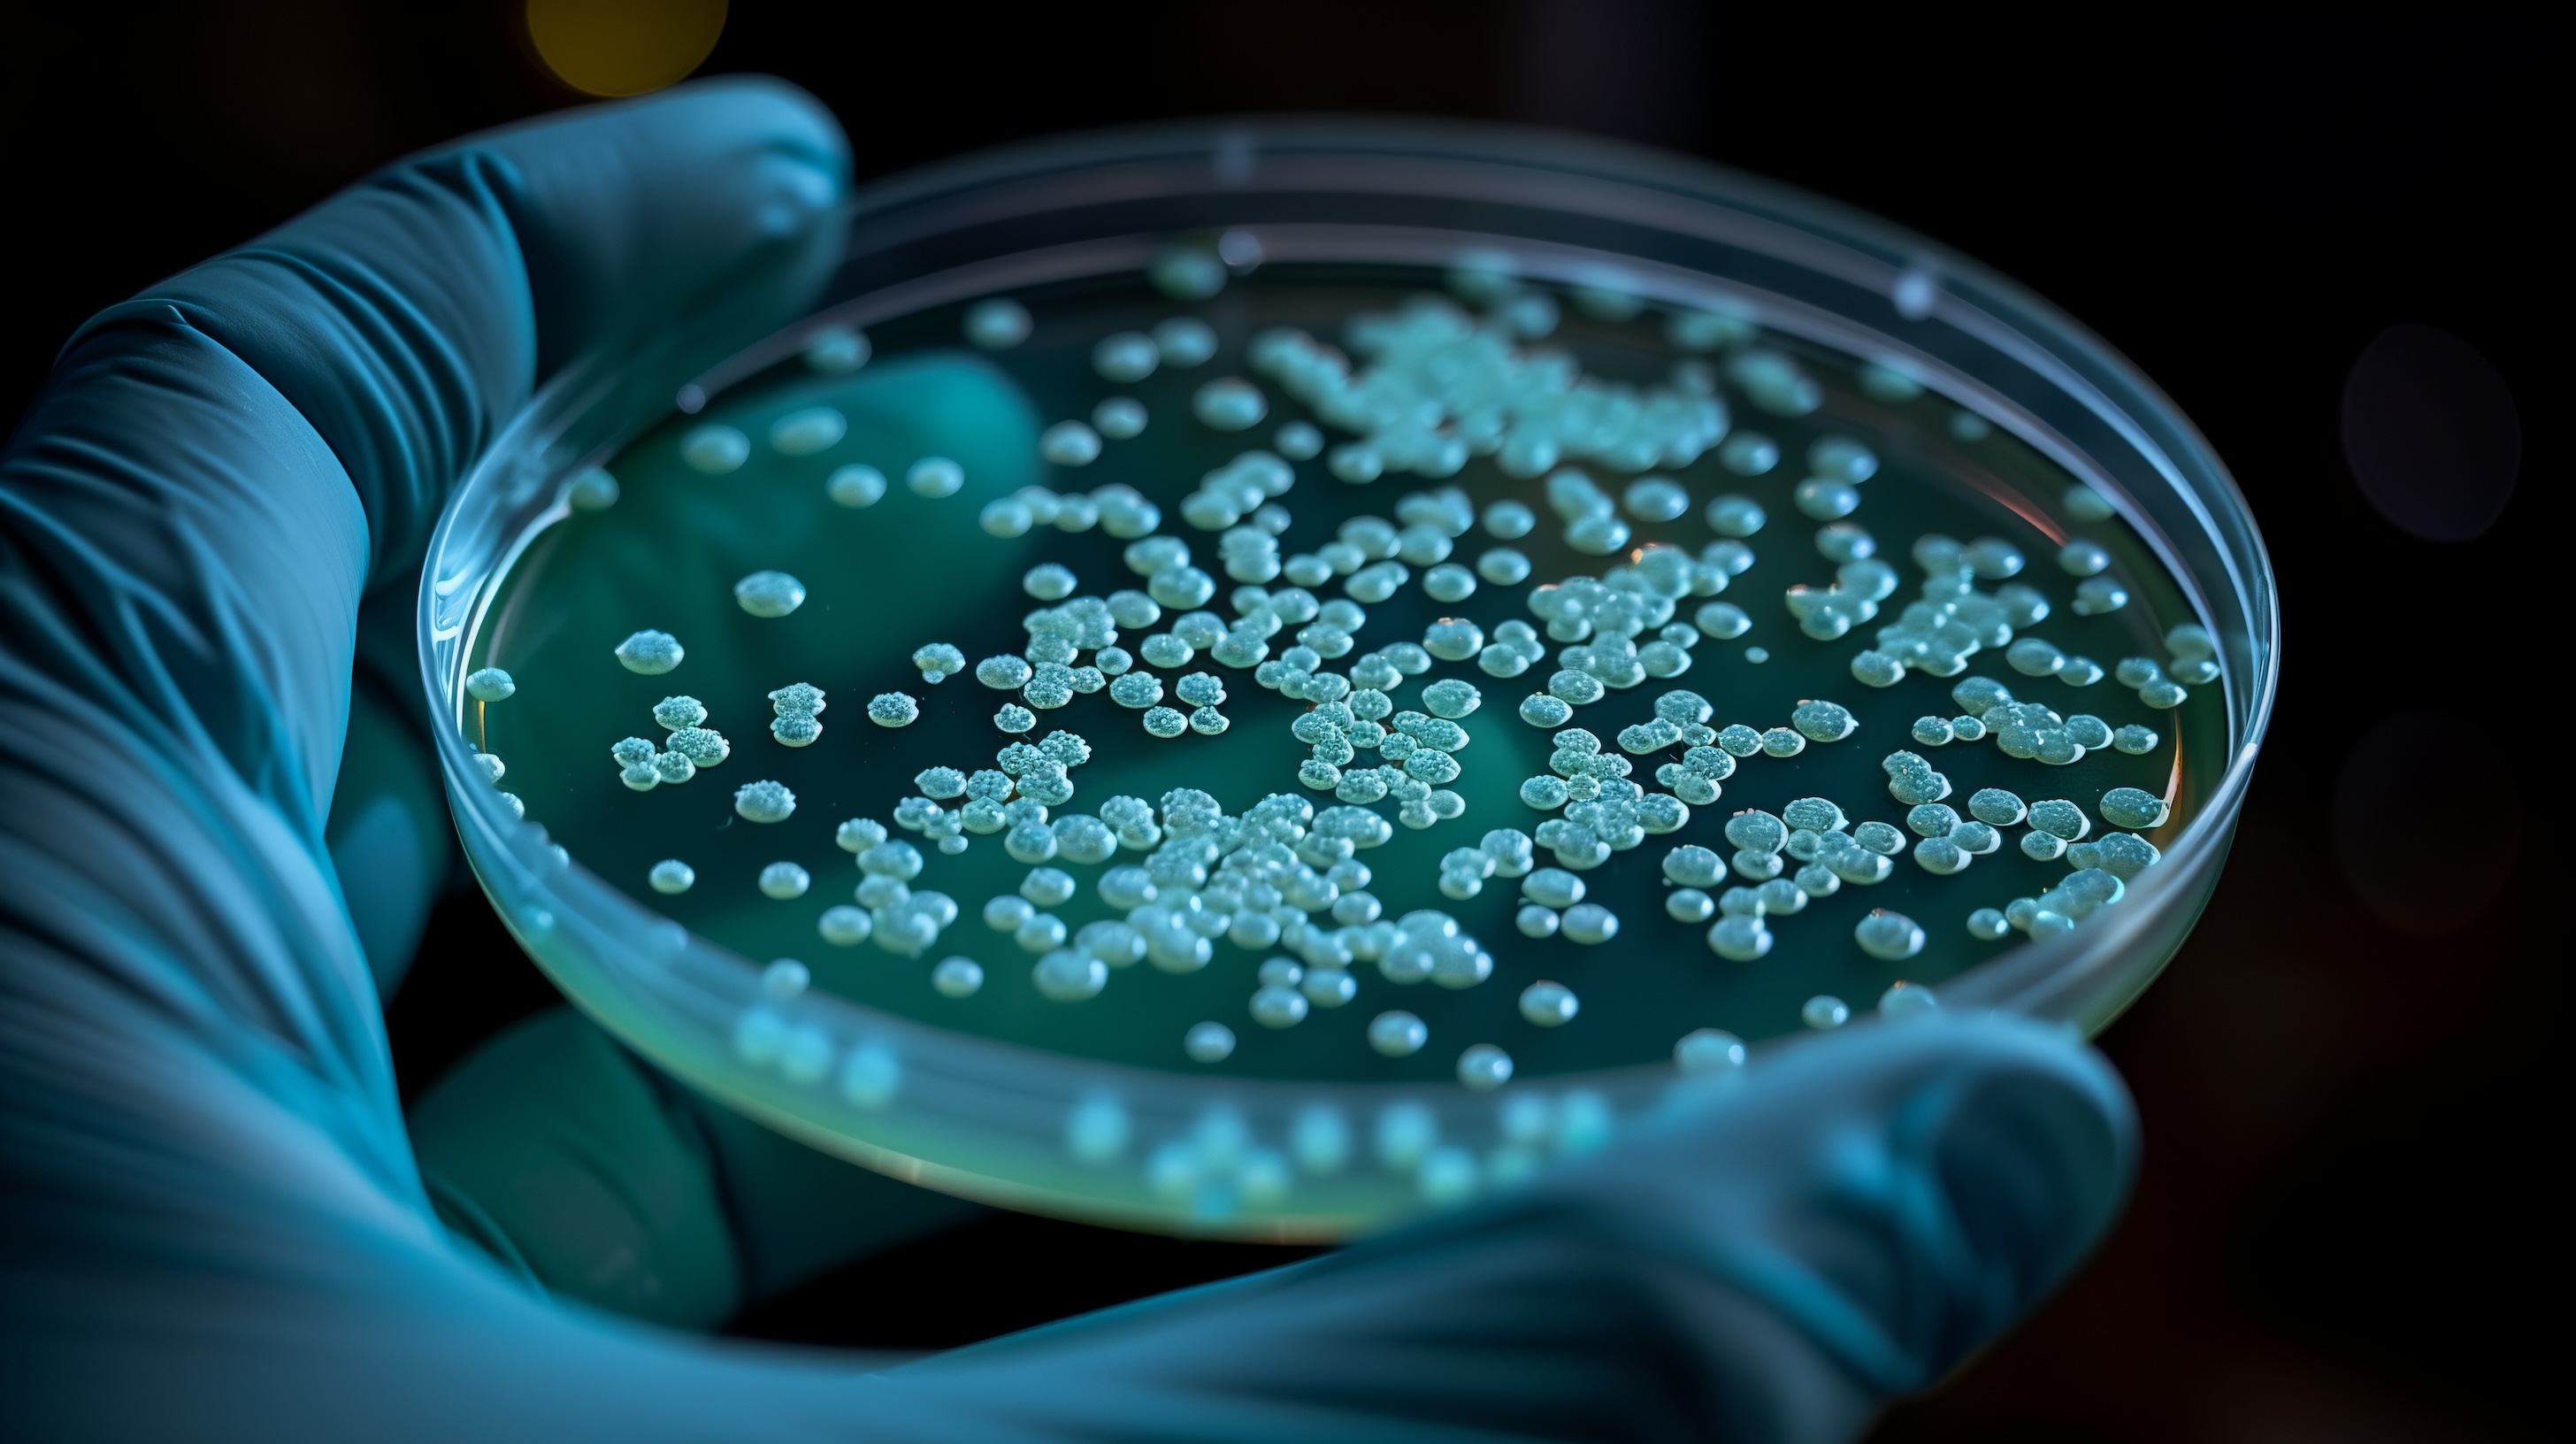

Re-engineering Cellular Stress Responses to Enhance Biomanufacturing of Difficult-to-Express Proteins

Our Epi-MAX platform uses omics-driven insights to eliminate biomanufacturing bottlenecks, enabling the efficient production of difficult-to-express proteins. We engineer custom strains to optimize protein production while maintaining biofidelity by understanding how cellular stresses, such as those from recombinant protein expression, affect productivity.
Our mission is to drive the affordable, sustainable, and widespread production of recombinant proteins that contribute to improved global health and nutrition.
The Epi-MAX Platform An integrated suite of omics and analytics tools to engineer cells and their genes for high yielding protein production by leveraging novel insights into cellular stress response mechanisms and tRNA reprogramming during biomanufacturing

Applications

Scalable Protein Production
Strain Engineering

mRNA Therapeutics
Our Differentiating Factors
About Us
We are scientists, engineers, and entrepreneurs from MIT and the University at Albany with an extensive track record of discoveries and publications related to stress-induced reprogramming of cells and their epitranscriptomes. We are determined to apply our expertise to solve universal issues that plague protein manufacturing to make biologics and cellular agriculture proteins affordable and accessible to all for the betterment of global health and nutrition.
 Robust
Robust
 Bespoke
Bespoke
 Empirical
Empirical
 Versatile
Versatile
 Data-Driven
Data-Driven
 Coordinated
Coordinated